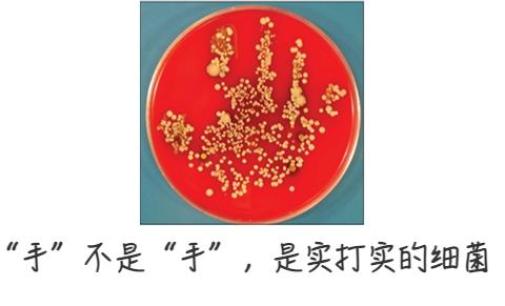

11月29日0-24时,新增报告本土确诊病例34例(轻型31例、普通型3例),其中渭南15例、西安4例(均为无症状转确诊)、延安4例、韩城3例、咸阳2例(均为无症状转确诊)、安康2例、汉中2例、铜川1例、榆林1例;新增报告本土无症状感染者767例,其中西安310例、榆林186例、安康60例、宝鸡58例、商洛46例、咸阳43例、渭南23例、延安18例、汉中12例、铜川7例、韩城2例、杨凌2例。出院54例、解除隔离医学观察382例。
截至11月29日24时,现有在院隔离治疗本土确诊病例543例、隔离医学观察无症状感染者9204例。
本土确诊病例情况:
1-15:渭南市报告,其中6例为高风险区筛查发现、4例为集中隔离发现、2例为省外输入居家隔离发现、2例为省外输入集中隔离发现、1例为居家隔离发现。
16-19:西安市报告,均为无症状感染者转确诊。
20-23:延安市报告,其中2例为省外输入集中隔离发现、1例为集中隔离发现、1例为居家隔离发现。
24-26:韩城市报告,其中1例为集中隔离发现、1例为省外输入集中隔离发现、1例为省外输入落地检发现。
27-28:咸阳市报告,均为无症状感染者转确诊。
29-30:安康市报告,均为集中隔离发现。
31-32:汉中市报告,其中1例为集中隔离发现、1例为高风险区筛查发现。
33:铜川市报告,为集中隔离发现。
34:榆林市报告,为集中隔离发现。
本土无症状感染者情况:
1-310:西安市报告,其中132例为集中隔离发现、51例为居家隔离发现、33例为社区筛查发现、33例为省外输入集中隔离发现、24例为省外输入居家隔离发现、10例为非闭环管理重点人员筛查发现、7例为闭环管理重点人员筛查发现、6例为高风险区筛查发现、5例为省外输入落地检发现、4例为居家健康监测发现、4例为主动就检发现、1例为主动就诊发现。
311-496:榆林市报告,其中116例为居家隔离发现、66例为集中隔离发现、3例为高风险区筛查发现、1例为跨区域协查发现。
497-556:安康市报告,其中32例为集中隔离发现、17例为居家隔离发现、9例为省外输入集中隔离发现、2例为高风险区筛查发现。
557-614:宝鸡市报告,其中31例为集中隔离发现、11例为高风险区筛查发现、6例为非闭环管理重点人员筛查发现、4例为省外输入集中隔离发现、4例为省外输入居家隔离发现、2例为居家隔离发现。
615-660:商洛市报告,其中30例为集中隔离发现、10例为省外输入集中隔离发现、2例为居家隔离发现、2例为跨区域协查发现、2例为社区筛查发现。
661-703:咸阳市报告,其中25例为集中隔离发现、3例为居家隔离发现、3例为社区筛查发现、3例为省外输入集中隔离发现、2例为非闭环管理重点人员筛查发现、2例为跨区域协查发现、2例为省外输入居家隔离发现、1例为闭环管理重点人员筛查发现、1例为省外输入闭环管理重点人员筛查发现、1例为省外输入非闭环管理重点人员筛查发现。
704-726:渭南市报告,其中9例为高风险区筛查发现、7例为居家隔离发现、4例为集中隔离发现、1例为社区筛查发现、1例为省外输入居家隔离发现、1例为省外输入集中隔离发现。
727-744:延安市报告,其中9例为集中隔离发现、3例为居家隔离发现、2例为闭环管理重点人员筛查发现、2例为社区筛查发现、1例为省外输入闭环管理重点人员筛查发现、1例为省外输入集中隔离发现。
745-756:汉中市报告,其中10例为高风险区筛查发现、2例为省外输入集中隔离发现。
757-763:铜川市报告,均为集中隔离发现。
764-765:韩城市报告,其中1例为集中隔离发现、1例为省外输入落地检发现。
766-767:杨凌示范区报告,其中1例为集中隔离发现、1例为非闭环管理重点人员筛查发现。
以上确诊病例、无症状感染者均在定点医疗机构隔离治疗、隔离医学观察,病例详情、活动轨迹和疫情防控工作情况由相关涉疫市(区)发布。
11月29日0-24时,新增报告境外输入确诊病例1例、无症状感染者4例。出院2例。
截至11月29日24时,现有在院隔离治疗境外输入确诊病例15例,隔离医学观察无症状感染者17例。
境外输入确诊病例1和无症状感染者1-4:入境后即被闭环管理,无陕西省内自行活动轨迹,核酸检测结果阳性,经市级专家组诊断为新冠肺炎确诊病例或无症状感染者,目前在定点医疗机构隔离治疗或医学观察。
健康提示:当前疫情形势严峻复杂,倡导广大群众牢固树立“每个人是自己健康的第一责任人”的理念,对自己健康负责,疫情期间从严做好个人防护和健康监测,戴口罩、勤洗手、不扎堆、少聚集,若有发热、咳嗽等不适症状,请及时到就近医院发热门诊就医,并及时核酸检测。积极接种新冠疫苗,防感染、防重症。严格遵守疫情防控法律法规、政策规定,积极配合落实疫情防控措施。对影响疫情防控秩序、违反疫情防控规定的行为,将依法严肃查处,公开曝光。
石泉县紧急寻人
经医学流行病例调查显示,我县一名初筛阳性人员于2022年11月27日乘坐公共交通工具通行,现将其乘车轨迹公布如下:
11月27日上午06:00时至10:00时在广场北路公交车站逗留,10:00时乘坐车牌号为陕GA0666的公交客运车从石泉广场北路出发至6号桥,10:25时转乘车牌号为陕GG8888公交客运车于中午12:00时左右到达熨斗镇集镇新街并就地落实管控措施。
现紧急寻找与该人员主要活动轨迹存在同时段、同车次的交集人员,并请交集人员立即主动向所在村(社区)或单位报备,不外出、不聚集、不乘坐公共交通工具,尽快就近开展一次核酸检测,配合落实疫情管控措施。如有瞒报、谎报造成严重后果的,将依法追究责任。
请广大居民不信谣、不造谣、不传谣,做好个人防护,坚持佩戴口罩、勤洗手、常通风、不聚集,保持安全社交距离,按时参加核酸检测,主动配合落实疫情防控措施。如出现发热、咳嗽等症状,要立即前往发热门诊就诊,并如实告知旅居史,就医过程中避免乘坐公共交通工具。
石泉县新冠肺炎疫情联防联控工作指挥部办公室
2022年11月29日
汉滨区高风险区最新调整
根据《新型冠状病毒肺炎防控方案(第九版)》关于科学划分风险区、精准管控等要求,结合国务院联防联控机制综合组发布《关于进一步优化新冠肺炎疫情防控措施科学精准做好防控工作的通知》(联防联控机制综发〔2022〕101号)精神,经研判,自2022年11月29日上午7时起,将五里镇梅花石村9组、滨月花苑5号楼,老城街道大北社区龙窝街58号调整为高风险区。调整后汉滨区有高风险区21个。
1.新城街道澜悦湾6号楼;
2.新城街道金洲城小区12号楼1单元;
3.新城街道骆家庄小区10号楼;
4.新城街道巴山中路82号乡企局家属楼2单元;
5.新城街道心石村180、183、187号;
6.新城街道长兴小区30号楼1单元;
7.新城街道兴安东路飞康果品超市;
8.老城街道沙帽石街56号;
9.老城街道安悦街70号影视大厦2单元;
10.老城街道大北街38、41号;
11.老城街道大北社区龙窝街58号;
12.建民街道长岭社区2号楼;
13.江北街道寇家沟社区14号楼;
14.五里镇滨月花苑25号楼1单元;
15.五里镇滨月花苑5号楼;
16.五里镇西桥村4组;
17.五里镇梅花石村9组;
18.茨沟镇景家社区安置点45号、49号;
19.瀛湖镇大明村3组、4组;
20.瀛湖镇天柱山村二组83号;
21.瀛湖镇瀛湖街道尚惠购物广场。
汉滨区新冠肺炎疫情
联防联控工作指挥部办公室
2022年11月29日
紫阳县新冠肺炎疫情防控指挥部
关于调整高风险区的通告
根据国务院应对新型冠状病毒肺炎疫情联防联控机制综合组《新型冠状病毒肺炎疫情防控方案(第九版)》及《关于进一步优化新冠肺炎疫情防控措施科学精准做好防控工作的通知》(联防联控机制综发〔2022〕101号)相关规定,经研究,现将风险区调整如下:
1.紫阳县城关镇仁和社区一期29号楼二单元
2.紫阳县城关镇仁和社区二期3号楼一单元
3.紫阳县城关镇紫阳中学高中部对面糖业烟酒公司家属楼
4.紫阳县城关镇西关夜市二楼小郡肝串串火锅店
5.紫阳县城关镇圆门口巷下端老卫生局家属院
6.紫阳县城关镇粮贸大楼二单元
7.紫阳县城关镇紫邑新城13号楼二单元
8.紫阳县城关镇紫邑新城12号楼
9.紫阳县城关镇西关夜市小李砂锅店
10.紫阳县城关镇万都百货电玩城
11.紫阳县城关镇圆门口巷林业局家属楼一单元
12.紫阳县城关镇紫源山庄1号楼四单元
13.紫阳县城关镇紫源山庄2号楼
14.紫阳县城关镇桥沟路李昌贵开发楼
15.紫阳县城关镇西关夜市二楼花甲米线
16.紫阳县城关镇仁和国际社区4号楼
17.紫阳县城关镇川国面都(紫邑新城店)
18.紫阳县城关镇建司巷7号楼
19.紫阳县城关镇钟鼓湾楠木小区1号楼一单元
以上19个高风险区自2022年11月30日12时起,调整为低风险区。
紫阳县新冠肺炎疫情防控指挥部
2022年11月30日
汉阴县新冠肺炎防控工作指挥部办公室
关于解除高风险区的公告
(第5号)
根据《新型冠状病毒肺炎防控方案(第九版)》关于科学划分风险区、精准管控等要求,结合国务院联防联控机制综合组发布《关于进一步优化新冠肺炎疫情防控措施科学精准做好防控工作的通知》(联防联控机制综发〔2022〕101号)精神,经研判,2022年11月29日0时起,涧池镇五星村全村解除高风险区,汉阴县全域实施常态化防控措施。
汉阴县新冠肺炎防控工作指挥部办公室
2022年11月29日
汉滨区严厉打击在疫情防控期间
哄抬物价等违法行为
为确保全区疫情防控期间生活物资市场平稳,有序维护市场秩序和社会稳定,保障人民群众生命健康安全,防止少数不良商家在此期间哄抬物价,损害人民群众切身利益。
11月29日,汉滨区经贸局、汉滨区发改局、汉滨区市场监管局联合出台文件,将严厉打击在疫情防控期间哄抬物价等违法行为。
文件明确,依据《中华人民共和国价格法》《中华人民共和国消费者权益保护法》《关于商品和服务实行明码标价的规定》等相关法律规定,在疫情防控期间,经营与人民群众日常生活相关的米、面、粮、油、肉、蛋、奶、禽、蔬菜等生活必需品必须进行明码标价,销售价格以发改部门公布的价格为参考,严格按照规定标准在合理进销差价率内执行,严禁囤积居奇、哄抬物价。
外卖平台配送费、跑腿费等费用收取不得随意涨价、恶意加价,严格执行公示的价格。
同时要做好宣传引导,保障物资供应充足。严禁在疫情防控期间捏造、散布“严重缺货”等谣言。市场监管、发改、经贸等相关部门将严格对上述商品价格执行情况进行监督检查。
对疫情管控期间出现的米、面、粮、油、肉、蛋、奶、禽、蔬菜等生活必需品哄抬物价,对在居民小区配送物资中使用低劣、伪劣、过期食品,对外卖平台配送费、跑腿费等费用随意涨价、恶意加价等各类违法行为,一经发现,将立即取消生活必需品保供企业资质,并依法从严从重从速查处。
汉滨区经贸局
汉滨区发改局
汉滨区市场监管局
2022年11月29日
镇坪县关于实行疫情防控线索
有奖举报的通告



疫情期间洗手真的能护体
关键做到这4步
↓↓↓
洗手是件小事
但真不能小看它
正确洗手是预防传染病
最有效、最便捷、最经济的方法之一
能预防1/3的腹泻相关疾病和1/5的感染

△ 底图来源:soogif
最重要的是
正确洗手是预防新冠肺炎病毒感染的
有效措施之一
在《新型冠状病毒肺炎防控方案(第九版)》中
《公民防疫基本行为准则》
将“勤洗手”放在了防护的第一位
01
看起来挺干净?
其实是一只“细菌手”!
有人一定会说,“哎呀,我的手看起来挺干净的!不用洗啦!”于是,嫌麻烦就没有洗。
这看起来挺“干净”的手,没准是只“细菌手”!
2017年,几项研究显示,医护人员在做——将患者从担架转移到床上、测量血压、测量患者脉搏、将患者重新抬到床上、接触患者的物品、打针——这些工作时,即便双手看起来挺干净的,但其实已经被污染。
在做上述的每一项工作中,医护人员的双手就可能接触到100~1000cfu的菌落数。
随后,将医护人员的手掌放在血琼脂培养基上,并在37°C下孵育24小时。可以看到的,细菌在细菌培养基的表面上长出了一张“手”!
△ 底图来源:《Bacteriological aspects of hand washing: A key for health promotion and infections control》
02
撸完狗没洗手
眼里长出一条2厘米的虫
今年10月19日,家住深圳的耿小姐感觉,最近一周时间,眼睛发痒、经常流泪。检查后,医生发现有条2厘米长的虫子在其眼结膜内蠕动。
医生用镊子将虫子挑了出来,经检验科化验发现是“结膜吸吮线虫”。据了解,结膜吸吮线虫主要寄生于犬、猫等动物眼结膜囊内,也可寄生于人眼,引起结膜吸吮线虫病。

△ 来源:荔枝新闻
原来,在1个月前,耿小姐曾在老家摸过村里的土狗,但摸完后没有洗手,就摸了自己眼睛和头发。所以,医生高度怀疑此线虫是当时沾染上的。最初,虫体幼小尚无明显症状,逐渐长大后便引起不适。
而且洗手可不是“冲一下”就完了~
如果洗得不对
那很可能就白洗了
▽
03
数学模型告诉你
洗手至少持续20秒
2021年8月,一位英国的数学家保罗·哈蒙德通过使用数学模型来探索洗手的物理原理。
该模型将皮肤的粗糙度表示为一对波浪形表面,由一层薄薄的液体隔开,擦洗时彼此移动。

△ 模型图来源:见水印
研究人员解释说,细菌和病毒等粒子会“藏”在手的粗糙表面中,因此水流动的强度必须足够大才能将它们“洗出来”。
而水流动的强度取决于搓手的速度,具体来说,更剧烈的运动才更容易去除粒子。
换句话说,我们需要用力洗手大约需要20秒才能去除所有潜在的细菌和病毒。

△ 底图来源:soogif
4个步骤教你正确洗手!
要勤洗手。
要使用肥皂或香皂或洗手液等洗涤剂。
要用流动的清水(用盆装水洗,那些脏东西冲不走,可能还会停留在手上)。
要揉搓双手持续20秒以上(唱2遍生日歌的时间)。

△ 底图来源:见水印
这些场景要及时洗手!
外出归来,戴口罩及摘口罩后;
清洁操作前,如饮食前、加工制作食品饮料前、触摸口鼻和眼睛前、护理老年人和婴幼儿前等;
污染操作后,如咳嗽、打喷嚏用手捂口鼻后、大小便后、护理病患后、触摸钱币后、接触或处理各种垃圾和污物后等;
手部有明显污染物;
传染病流行期间,触摸门把手、电梯按键等各类高频接触的物体表面后。

△ 底图来源:fabiaoqing
外出不方便时
可用免洗洗手液洗手
如果洗手时,没有流动水或肥皂,可以使用免洗洗手液,或者是酒精浓度在60%~80%的速干手消毒剂。按六步洗手法的步骤互相揉搓双手。在免洗洗手液干燥之前,不要擦拭掉或冲洗它,一直揉搓大约20秒。

△ 六步洗手法 图源:广东疾控
洗手液有“卫妆准字”和“卫消证字”两类,前者属于化妆品类,只有基本的清洁作用;后者属于消毒产品类,在清洁的基础上增加了抗(抑)菌或消毒作用,可根据需要选择。

△ 图源:自己拍的
疫情期间
正确洗手更是防疫的重要手段之一
与其生病了后难受
不如防范于未然
踏踏实实地去洗个手

安康市疫情防控指挥部办公室:0915-3319794
汉滨区疫情防控指挥部办公室:0915-3115299
汉阴县疫情防控指挥部办公室:0915-5215705
石泉县疫情防控指挥部办公室:0915-6321274
宁陕县疫情防控指挥部办公室:0915-2113277
紫阳县疫情防控指挥部办公室:0915-4412105
岚皋县疫情防控指挥部办公室:0915-2521118
平利县疫情防控指挥部办公室:0915-8424955
镇坪县疫情防控指挥部办公室:0915-8822747
旬阳市疫情防控指挥部办公室:0915-7771199
白河县疫情防控指挥部办公室:0915-7822259
安康高新区疫情防控指挥部办公室:0915-8181585
恒口示范区疫情防控指挥部办公室:0915-3613886

防疫措施千万条
戴口罩、勤洗手
最重要
原标题:《安康新增"2+60"!一地紧急寻人!两地高风险区调整!最新信息汇总》
阅读原文
本文来自作者[新闻资讯]投稿,不代表辣之友号立场,如若转载,请注明出处:https://lzysp.cn/wiki/202509-1768.html
评论列表(4条)
我是辣之友号的签约作者“新闻资讯”!
希望本篇文章《安康新增‘2+60’疫情动态:紧急寻人及高风险区调整最新信息汇总》能对你有所帮助!
本站[辣之友号]内容主要涵盖:国足,欧洲杯,世界杯,篮球,欧冠,亚冠,英超,足球,综合体育
本文概览:11月29日0-24时,新增报告本土确诊病例34例(轻型31例、普通型3例),其中渭南15例、西安4例(均为无症状转确诊)、延安4例、韩城3例、咸阳2例(均为无症状转确诊)、安...